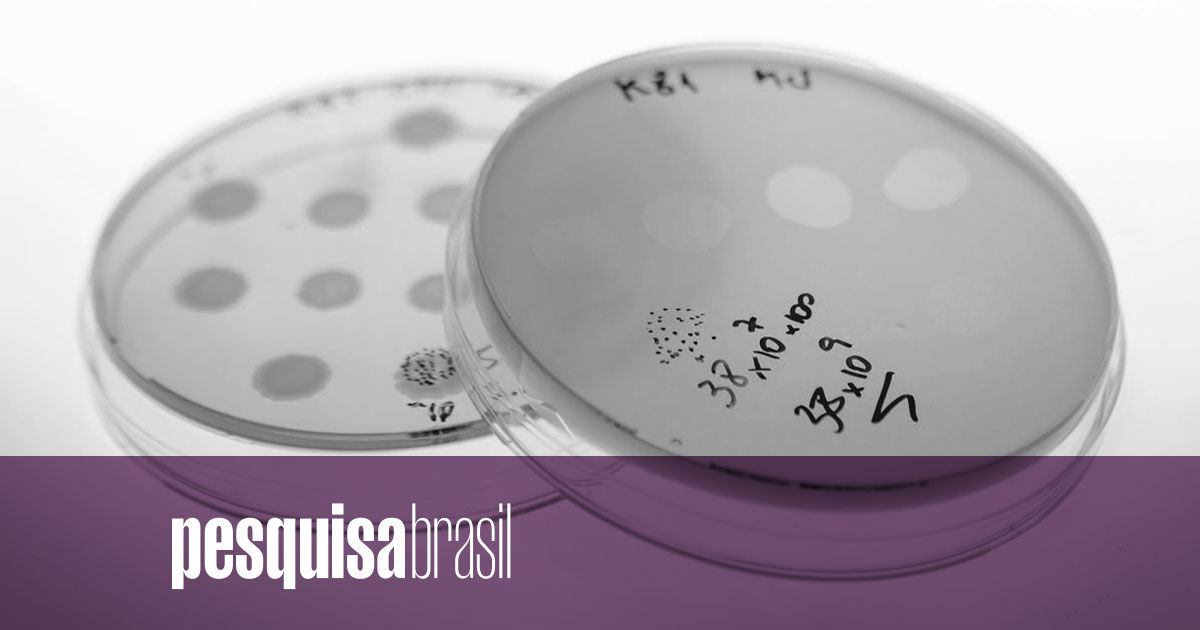

Ariosvaldo Pereira dos Santos Junior
- cipesbra
https://revistapesquisa.fapesp.br/ariosvaldo-pereira-dos-santos-junior/?utm_source=rss&utm_medium=rss&utm_campaign=ariosvaldo-pereira-dos-santos-junior
#Entrevistas #Biologia #Gentica #Medicina #SadePblica